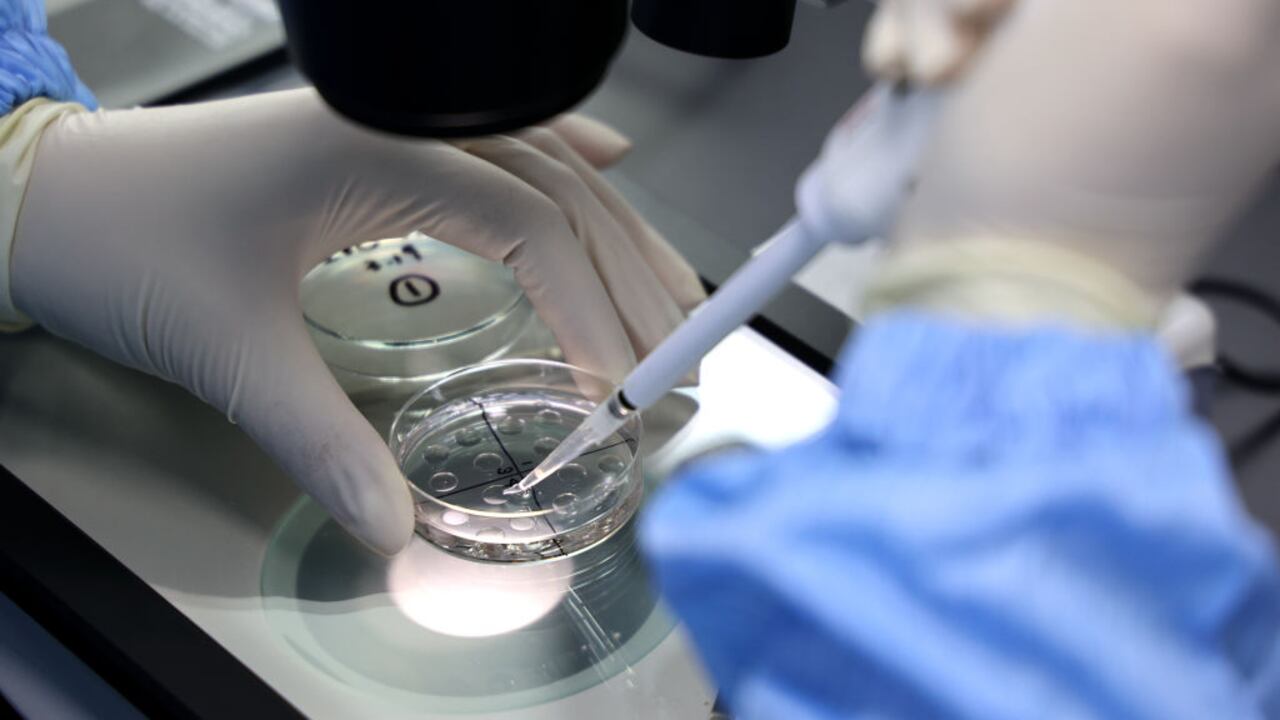
Un trabajador de laboratorio trabajando en una empresa de biotecnología en el condado de Yangxin, en la provincia de Shandong, en el este de China. Foto de CHU BAORUI / Feature China/Future Publishing vía Getty Images

SALUD
Este producto de uso diario podría causar cáncer: la OMS emitió una alerta
El reciente anuncio de la Organización Mundial de la Salud (OMS) genera preocupación entre millones de personas en el mundo.
Léenos en Google Discover y mantente un paso adelante con SEMANA
El talco fue clasificado como probablemente cancerígeno por la agencia para el cáncer de la Organización Mundial de la Salud (OMS), que también ha clasificado como cancerígeno el acrilonitrilo, un compuesto utilizado en la producción de polímeros.
Los expertos del Centro Internacional de Investigaciones sobre el Cáncer (CIRC/IARC), reunidos en Lyon (Francia), publicaron sus resultados el viernes en la revista The Lancet Oncology.
El talco, un mineral natural extraído en muchas regiones del mundo, es “probablemente cancerígeno” para los seres humanos, a partir de una combinación de estudios parciales en seres humanos (cáncer de ovario) y pruebas suficientes obtenidas a partir de animales de laboratorio.
Según esos expertos, la exposición ocurre principalmente en el entorno laboral durante la extracción, molienda o procesamiento del talco, o durante la fabricación de productos que lo contienen.
Para la población en general, la exposición ocurre principalmente a través del uso de cosméticos y polvos corporales que contienen talco.
No obstante, los expertos no descartan ciertos sesgos en los estudios que han mostrado un aumento en la incidencia de cáncer.
Aunque la evaluación se centró en el talco que no contiene amianto, no se podría excluir que el talco estuviera contaminado con amianto en la mayoría de los estudios con humanos.
En junio, el gigante farmacéutico estadounidense Johnson & Johnson (J&J) cerró un acuerdo definitivo con la justicia de 42 estados en Estados Unidos en un caso de talco acusado de haber causado cánceres.

Una síntesis de estudios, publicada en enero de 2020 y basada en 250.000 mujeres en Estados Unidos, no encontró un vínculo estadístico entre el uso de talco en las partes genitales y el riesgo de cáncer de ovario.
En la década de 1970 surgió una preocupación sobre la contaminación del talco con amianto, que a menudo se encuentra cerca de los minerales utilizados para fabricar talco.
Posteriormente, estudios señalaron un mayor riesgo de cáncer de ovario en las usuarias de talco.
La agencia de la OMS también ha clasificado como “cancerígeno” para los humanos el acrilonitrilo, un compuesto orgánico volátil utilizado principalmente en la producción de polímeros.
Esta decisión se basa en “pruebas suficientes de cáncer de pulmón” y “pruebas limitadas” de cáncer de vejiga en humanos, según la IARC.
Estos polímeros se utilizan en fibras para ropa, alfombras, plásticos para productos de consumo o piezas de automóviles.
El acrilonitrilo también está presente en el humo del cigarrillo. La contaminación del aire constituye otra fuente de exposición.
Por otra parte, en mayo del presente año, la Organización Mundial de la Salud, OMS, dio detalles sobre una nueva lista de patógenos bacterianos que son prioritarios para 2024. En dicho listado se destacan un total de 15 familias de bacterias resistentes a los antibióticos, las cuales están clasificadas en varios niveles de prioridad: crítica, alta y media.

No es una actualización cualquiera: la misma persigue orientar con precisión la investigación y el desarrollo de nuevos tratamientos para hacer frente a la creciente amenaza de la resistencia a los antimicrobianos.
Se trata de un grave problema de salud pública, toda vez que la resistencia a los antimicrobianos reduce la eficacia de los tratamientos y aumenta la morbimortalidad de las enfermedades infecciosas. Como consecuencia de ello, las enfermedades que generan son más graves y contagioso, por lo que el riesgo de que se propaguen representa una mayor amenaza para la salud humana.
Ahora bien, la OMS deja claro que el uso inadecuado y en exceso de los antibióticos se ha convertido en la principal causa de este fenómeno, que pone en riesgo los logros de la medicina moderna.
En la nueva lista de patógenos bacterianos de la OMS se adjuntaron pruebas muy recientes e información proporcionada por un grupo de expertos mundiales, que resulta de gran utilidad para llevar a cabo las investigaciones y posteriores desarrollos de nuevos antibióticos que fomenten la coordinación internacional e impulsen la innovación en materia de farmacología.

Tal como explica Yukiko Nakatani, quien se desempeña como subdirectora General interina de la OMS para la Resistencia a los Antimicrobianos, la lista de patógenos bacterianos prioritarios se basa en la carga global de infecciones por bacterias farmacorresistentes y su impacto en la salud pública.
Esta guía entonces resulta esencial para orientar las inversiones en este campo y superar los desafíos en la obtención de nuevos antibióticos para la humanidad. Es que la amenaza de la resistencia ha aumentado desde la publicación de la primera lista en el año 2017, lo que afecta la eficacia de los numerosos antibióticos. Una situación que llegaría a desestimar los importantes logros de la medicina más moderna.
*Con información de AFP